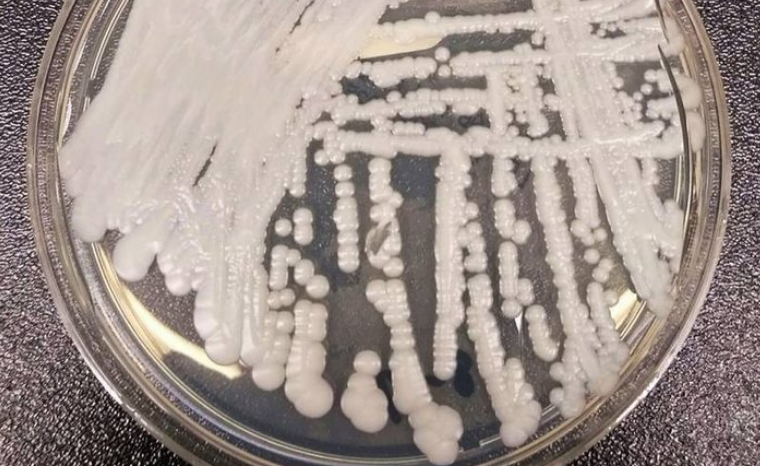

Identifié pour la première fois il y a une décennie, le Candida auris se propage facilement, surtout au niveau des personnes dont le système immunitaire est affaibli. Alors que le nombre de cas augmente, la question de la résistance aux médicaments se pose.
Un champignon tueur
Le Candida auris est un champignon Fungi qui se développe sous forme de levure. Celui-ci a été isolé pour la première fois en 2009 dans un hôpital japonais, présent dans l’oreille externe d’une patiente. Le fait est que depuis, les cas de « candidose » (infection par cette levure) n’ont cessé d’augmenter, la plupart du temps dans les hôpitaux et atteignant des patients au système immunitaire déjà affaibli.
Il y a quelques jours, le New York Times a relaté l’histoire du décès d’un patient en fin d’année 2018 au Mount Sinaï Hospital (New York). L’homme avait été admis pour une simple chirurgie abdominale et pourtant, les médecins ont ensuite décelé la présence du Candida auris dans son organisme. Après trois mois de quarantaine, le patient est décédé et de multiples traces du champignon ont été retrouvées dans sa chambre.

Un champignon résistant
Publiée en octobre 2018 dans la revue Emerging Infectious Diseases, une étude américaine s’est également intéressée au Candida auris. Cette enquête a compilé les informations concernant une cinquantaine de cas d’infections contractées par des patients dans des établissements de santé à New York entre 2013 et 2017. Or, près de la moitié de ces patients – ayant auparavant déjà eu des problèmes de santé – sont décédés dans les 90 jours suivant l’infection ! Surtout, il s’est avéré que 98 % des échantillons de Candida auris prélevés étaient résistants au fluconazole, un antifongique très utilisé. Par ailleurs, sur la vingtaine d’établissements de santé dans lesquels a été menée l’enquête, les levures ont été retrouvées dans les trois quarts !
La résistance aux antibiotiques est depuis des années un véritable problème de santé publique. Or, la surconsommation de ce genre médicaments réduirait leurs effets face à des germes de plus en plus résistants. En effet, les champignons – tout comme les bactéries – sont capables de développer des moyens de défense contre les traitements antifongiques administrés aux patients.
Ainsi, ces germes résistants peuvent être mortels pour les patients dont le système immunitaire est faible. Cela concerne donc les nourrissons, les personnes âgées, les personnes atteintes d’une maladie auto-immune, et potentiellement les diabétiques et autres fumeurs. Enfin, il n’est pas à exclure qu’un jour, ces infections puissent également concerner les personnes en bonne santé, à tel point que 10 millions de personnes pourraient en mourir d’ici à 2050.
Sources : The Straits Times – Medisite
Articles liés :